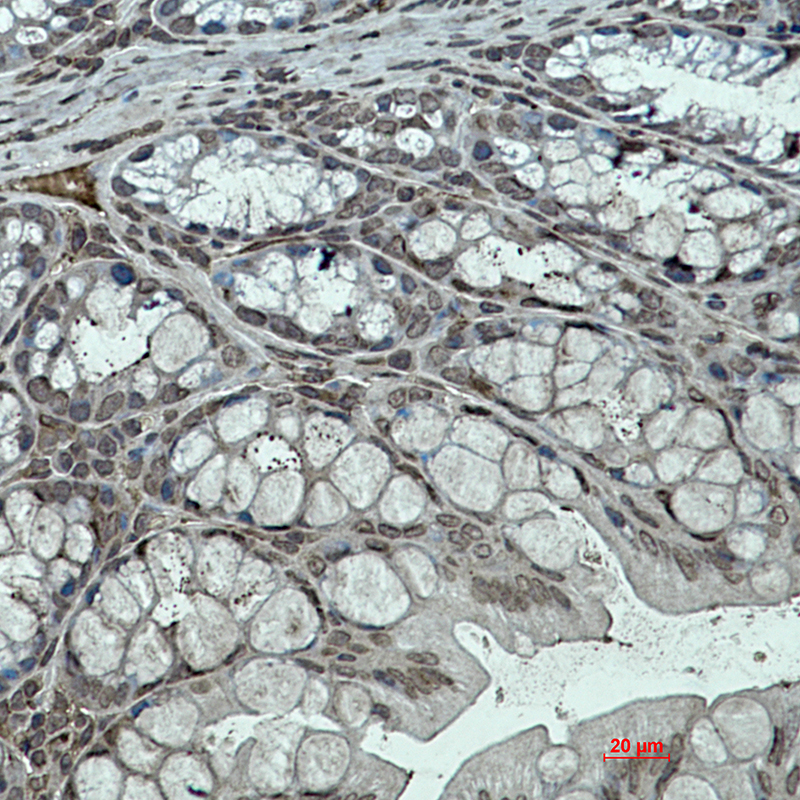

-
分类: 科研抗体货号: P22398别名: FAKTS; URLC9; hFLEG1应用: WB,IHC反应种属: Human
-
分类: 科研抗体货号: P22396别名: hHIPk2; Hipk2; Nbak1; Stank应用: WB,IP,IF反应种属: Human
-
分类: 科研抗体货号: P22412别名: BDA1; HHG2应用: WB,IHC反应种属: Human,Mouse
-
分类: 科研抗体货号: P22395别名: HINT1; HINT; PKCI1; PRKCNH1; Histidine triad nucleotide-binding protein 1; Adenosine 5'-monophosphoramidase; Protein kinase C inhibitor 1; Protein kinase C-interacting protein 1; PKCI-1应用: WB,IP,IF反应种属: Human
-
分类: 科研抗体货号: P22427别名: EZF; Zie; Gklf应用: WB,IP,IHC反应种属: Human,Mouse,Hamster
-
分类: 科研抗体货号: P22411别名: IGF1R; Insulin-like growth factor 1 receptor; Insulin-like growth factor I receptor; IGF-I receptor; CD antigen CD221应用: WB,IHC反应种属: Human
-
分类: 科研抗体货号: P22394别名: FIH 1; FIH1; HIF1AN应用: WB,IHC,IF反应种属: Human
-
分类: 科研抗体货号: P22426别名: KAP3; KIF3AP; Kifap3; Kinesin associated protein 3; SMAP应用: WB,IHC反应种属: Human,Rat
-
分类: 科研抗体货号: P22410别名: IGF1R; Insulin-like growth factor 1 receptor; Insulin-like growth factor I receptor; IGF-I receptor; CD antigen CD221应用: WB,IP反应种属: Human
-
分类: 科研抗体货号: P22393别名: ARNT; BHLHE2; Aryl hydrocarbon receptor nuclear translocator; ARNT protein; Class E basic helix-loop-helix protein 2; bHLHe2; Dioxin receptor; nuclear translocator; Hypoxia-inducible factor 1-beta; HIF-1-beta; HIF1-beta应用: WB,IHC反应种属: Human,Mouse,Rat,Hamster

鄂公网安备42018502007531号
鄂公网安备42018502007531号

